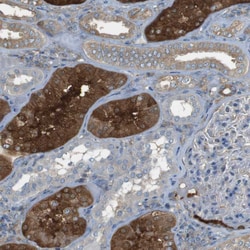
Invitrogen PEPD Polyclonal Antibody 100 &mu;L; Unconjugated:Antibodies,

missing translation for 'onlineSavingsMsg'
Learn More
Learn More
Invitrogen™ PEPD Polyclonal Antibody


Rabbit Polyclonal Antibody
Brand: Invitrogen™ PA553335
This item is not returnable.
View return policy
Description
Immunogen sequence: ITCSFPANGK FTADQKAVYE AVLRSSRAVM GAMKPGVWWP DMHRLADRIH LEELAHMGIL SGSVDAMVQA HLGAVFMPHG LGHFLGIDVH DVGGYPEGVE RIDEPGLRSL RTARHLQPGM VLTVEPGIYF IDHLLDE Highest antigen sequence identity to the following orthologs: Mouse - 90%, Rat - 36%.
Xaa-Pro dipeptidase is a cytosolic dipeptidase that hydrolyzes dipeptides with proline or hydroxyproline at the carboxy terminus (but not Pro-Pro). It is important in collagen metabolism because of the high levels of iminoacids. Xaa-Pro dipeptidase is a cytosolic dipeptidase that hydrolyzes dipeptides with proline or hydroxyproline at the carboxy terminus (but not Pro-Pro). It is important in collagen metabolism because of the high levels of iminoacids.
Specifications
| PEPD | |
| Polyclonal | |
| Unconjugated | |
| PEPD | |
| aminoacyl-L-proline hydrolase; cb1000; dal; fj78g11; Imidodipeptidase; MGC10905; Pep4; Pep-4; Pepd; Peptidase 4; peptidase D; PRD; Prolidase; proline dipeptidase; testicular tissue protein Li 138; wu:fj78g11; xaa-Pro dipeptidase; X-Pro dipeptidase | |
| Rabbit | |
| Antigen affinity chromatography | |
| RUO | |
| 18624, 292808, 5184 | |
| Store at 4°C short term. For long term storage, store at -20°C, avoiding freeze/thaw cycles. | |
| Liquid |
| Immunohistochemistry (Paraffin), Western Blot, Immunocytochemistry | |
| 0.1 mg/mL | |
| PBS with 40% glycerol and 0.02% sodium azide; pH 7.2 | |
| P12955, Q11136, Q5I0D7 | |
| PEPD | |
| Recombinant protein corresponding to Human PEPD. Recombinant protein control fragment (Product #RP-90665). | |
| 100 μL | |
| Primary | |
| Human, Mouse, Rat | |
| Antibody | |
| IgG |
Product Content Correction
Your input is important to us. Please complete this form to provide feedback related to the content on this product.
Product Title
Spot an opportunity for improvement?Share a Content Correction